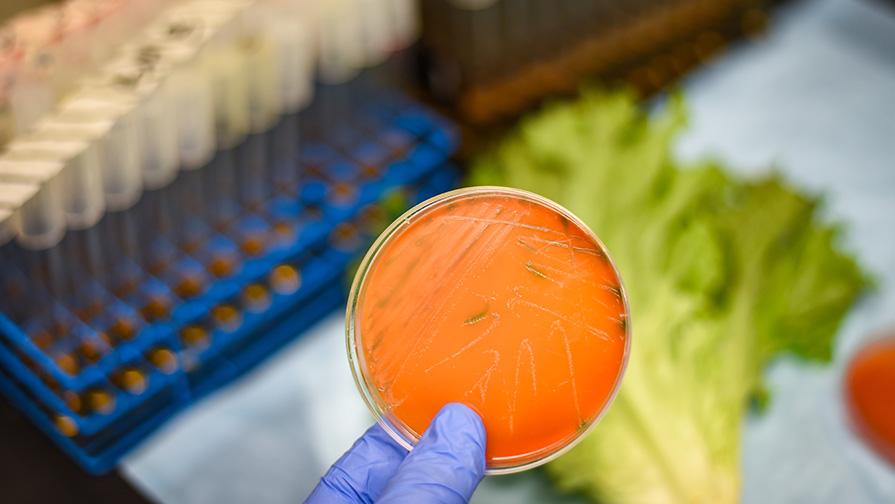
Omnivore EP 14 scientist holding a petri dish

EP 14: The Art of Science Communication
- Omnivore
- EP 1: Salary and Career Trends
- EP 2: Foodservice Menu Upgrades
- EP 3: 2023 Consumer Market Outlook
- EP 4: Sandwiches on the Menu
- EP 5: Plant-Based Meat Challenges
- EP 6: Center Store Stats
- EP 7: Regenerative Ag
- EP 8: Nutrition for the Ages
- EP 9: Food Safety Change Agent
- EP 10: The Jack in the Box Effect
- EP 11: Clean Label Seasonings
- EP 12: Climate-Friendly Snacks
- EP 13: Fighting Food Fraud
- EP 14: The Art of Science Communication
- EP 15: Mars CSO Abigail Stevenson
- EP 16: Campbell’s Innovation Engine
- EP 17: Sustainable Product Positioning
- EP 18: Generational Marketing
- EP 19: Josh Tetrick on Cultivated Meat
- EP 20: Coca-Cola's Jason Richardson
- EP 21: Disruption in the Backseat
- EP 22: Frank Yiannas on Netflix’s Poisoned
- EP 23: Cultural Appropriation in R&D
- EP 24: IFT Appert Award Winner
- EP 25: Regenerative Ag
- EP 26: The Art of Science Communication
- EP 27: What Consumers Want 2024
- EP 28: FDA Talks Traceability, Part 2
- EP 29: 2024 Consumer Trends
- EP 30: PFAS BVO Heavy Metals
- EP 31: Alternative Snacks
- EP 32: Hurdling FSMA 204 Challenges
- EP 33: Ag Futurist Robert Saik
- EP 34: Food Systems Changemaker
- EP 35: Global Food System Challenge
- EP 36: Exploring ‘Nutrition’s Dark Matter’
- EP 37: The Future of Product Innovation
- EP 38: Food as a Healing Agent for Change
- EP 39: Career Insights from a Recruiter
- EP 40: DIY Food Manufacturing
- EP 41: Why Cultivated Meat Bans Are a Bad Idea
- EP 42: Inside Food Safety Risk
- EP 43: Insect-Inspired Tech
- EP 44: Supply Chain Resiliency at IFT FIRST
- EP 45: 2025 Flavor Outlook
- EP 46: Making Bean Flour More Functional
- EP 47: 2024 Tech Trends Outlook
- EP 48: The Ins and Outs of Indoor Agriculture
- EP 49: Ag Futurist Robert Saik, @TheBlackFoodScientist Shares the Science, The Potential of Generative AI
- EP 50: Building Trust in Food Science, Food As Medicine, Food Safety Tech Game-Changers
- EP 51: Talking Trends With Mintel’s Jenny Zegler, Traceability Rule Challenges, Legacy Brands Product Innovation
- EP 52: 2025 Food Industry M&A Forecast, 2025 Food Safety Trends, Securing Research Funding
- EP 53: A Food Scientist Processes Nova and UPFs
- EP 54: Honey's Aroma and Sweetness
- EP 55: Rethinking Approaches to Obesity
- EP 56: Sensory Science in Africa
- EP 57: Hottest Trends in Functional Foods
- EP 58: Getting Your Résumé Right
- EP 59: Building a Better Food Ecosystem
- SciDish May 2025: Insider Tips on Launching Your Food Science Career
- EP 60: African Food Trend Heats Up
- EP 61: Riding the AI Wave, The Iron Man Speaks
- SciDish June 2025: Food Safety 2025: Insights on Recalls, Risks, and Resilience
- EP 62: Time to Act on Traceability, Novel Technology Could Improve Wheat Processing
- EP 63: Exploring the MAHA Report
- SciDish July 2025: Scientific Skinny
- EP 64: Open Innovation for Food System Transformation
- EP 65: Cultivated Meat Innovator
- SciDish August 2025: Research Integrity
- EP 66: Navigating Supply Chain Volatility
- EP 67: Scaling Food As Medicine
- SciDish September 2025: Delivering Nutrition
- EP 68: How Plantible Foods Is Unlocking the Power of Plants
- EP 69: UPFs and the Question of Hyper-Palatability
- SciDish October 2025: Myth Busting Misinformation
- EP 70: Flavor Trends for 2026 and Beyond
- EP 71: Understanding the New Mainstream Consumer
- SciDish November 2025: Tech Innovations for Food Security
- EP 72: Trend Talk with Maeve and Mike
- EP 73: Decoding Consumers’ Food Behaviors
- Best of SciDish 2025
- EP 74: Best of Omnivore 2025
- SciDish January 2026: Consumer Trends
- EP 75: GLP-1 Trend Gets Hotter, Rethinking UPF Myths and Mechanisms
- SciDish Feb 2026 Post-GLP-1 Food Innovation
- EP 76: Deconstructing America’s New Dietary Guidance
In the June episodes of Omnivore, Food Technology magazine’s award-winning editors bring you into the room with a not-to-be-missed line-up of food scientists and industry thought leaders.
Science communication expert Laura Lindenfeld explains how theatrical improv can help scientists break down barriers and better covey complex ideas. Researchers Anne Plotto and Matthew Mattia describe their efforts to overcome the impact of citrus greening disease by developing orange tree hybrids that produce fruit that is both delicious and disease resistant. While there are a lot of benefits organic acids bring to the product formulation and processing table, as microbiologist Erdogan Ceylan tells us, there are a few watchouts when applying these compounds to different food matrices.
Plus: Find out how Kalsec’s DuraShield Natural Food Protection Blends help extend shelf life while keeping your meat or poultry product's label clean.
Listen and subscribe on Apple Podcasts, Google Podcasts, Spotify, or wherever you listen to podcasts.
GUESTS

Laura Lindenfeld, PhD, is executive director of the Alan Alda Center for Communicating Science and Dean of the School of Communication & Journalism at Stony Brook University. With co-author Fabio Parasecoli, she explores the intersection of food and popular culture in her book, “Feasting Our Eyes: Food Films and Cultural Identity in the United States.”

Anne Plotto, PhD, is a research plant physiologist with the U.S. Department of Agriculture’s Agricultural Research Service at the U.S. Horticultural Research Laboratory in Fort Pierce, Fla. Her current research focuses on flavor analysis and sensory evaluation of fruit and fruit products as affected by genotype, postharvest conditions, and processing. Currently, her main focus is evaluating flavor of citrus hybrids tolerant to the citrus greening disease.

Matthew Mattia, PhD, is a research geneticist with the U.S. Department of Agriculture’s Agricultural Research Service at the U.S. Horticultural Research Laboratory in Fort Pierce, Fla. He is a plant breeder and horticulturalist who has started and led several breeding programs in a wide range of crop species. His current emphasis is breeding new citrus scion varieties.

Erdogan Ceylan, PhD, is director-scientific affairs with Mérieux NutriSciences and chair of IFT’s Refrigerated and Frozen Foods Division. He is an award-winning food safety and quality executive with 25 years of experience in industrial research, food processing, operational food safety issues, troubleshooting, crisis management and regulatory affairs.

Omnivore Podcast
Join the award-winning editors of Food Technology Magazine every other Monday for Omnivore, the podcast that intersects the business of food and the science of food, through lively discussion and interviews with product innovators, leading researchers, policy makers, and thought leaders from across the world of food.

